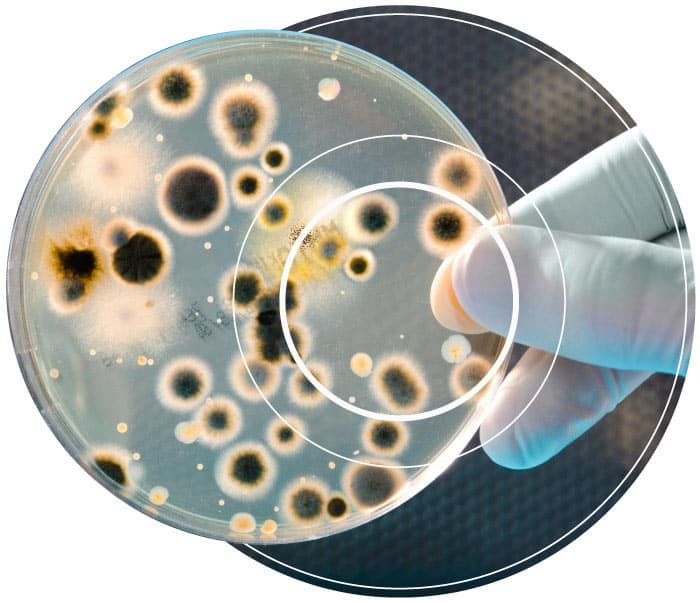

Description
Unlike traditional tests, FUELSTAT® only finds micro-organisms that do damage to fuel.
With FUELSTAT®, tests take as little as 15 minutes, unlike current growth-based tests that need at least 72 hours. With easy-to-understand alert levels, you instantly know whether you need to take further action.
The process is self-contained, requiring no additional equipment—just a single FUELSTAT® fuel testing kit for each test. It’s so easy to use, that a single individual can carry out the tests with only minimal training.
FUELSTAT FHR8-2 Aviation Fuel PLUS: DEPENDABLE RESULTS, EVEN IN THE DIRTIEST CONDITIONS
- Ultra simple test that requires 4 drops of sample
- 15 minutes to result as opposed to 4-7 days!
- Unique immunoassay antibody technology
- Detects only specific microorganisms
- Carried out on site, so complying with ASTM D6469 – testing for contamination within 24 hours
- Avoids time delays and expense associated with sample transportation to laboratory
CONTACT US for bulk pricing
WHAT ARE FUEL TESTING KITS USED FOR?
Some of the most commonly used tests are the ones that detect microbiological contamination in diesel, jet fuel and all related derivatives.
This microbiological contamination is also known as diesel bug or diesel fungus. In jet fuel, it’s known as jet fuel fungus.
Microbiological contamination is made up of certain strains of bacteria, yeasts, and fungi that are dangerous to fuel. These contaminants are particularly prevalent in middle distillate fuels, which we know as jet fuel and diesel fuel.
You can now get a fuel testing kit specifically for microbiological contamination, which enables you to identify contamination at the earliest possible stage. Treating contamination and the issues in the early stages is faster, cheaper, and less risky than it would be in later stages.
WHAT ISSUES DOES MICROBIOLOGICAL CONTAMINATION CAUSE?
- A tank builds up microbial matter until it can no longer be used and requires cleaning
- A generator engine fails to fire up because its filters are blocked by contamination (see Diesel Generator Fuel Testing)
- A fuel quantity indicator in an aircraft functions incorrectly because of a microbial biofilm coating the probes that read the fuel levels (see Aircraft Fuel Testing)
In a very serious scenario, microbial contamination can seriously damage tanks themselves. Left unchecked for too long, it can lead to Microbially Influenced Corrosion (MIC) of the tanks because of the acids it produces.
When microbial contamination reaches severe levels and produces these acids, it can lead to serious safety and environmental risks. For example, a large tank could develop a leak so that fuel escapes into the ground. Or in the case of commercial aircraft, a severe blockage could cause engine failure and put human life at risk.